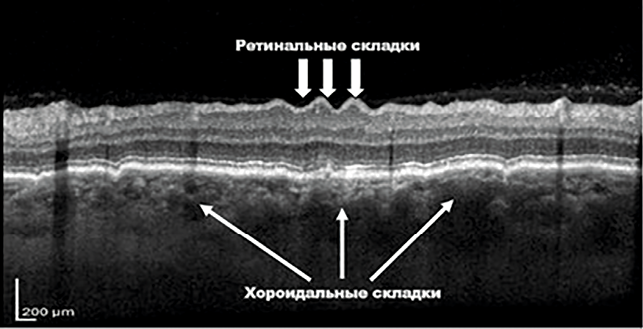

As human spaceflight missions grow longer and ambitions for interplanetary travel move closer to reality, understanding the effects of microgravity on astronaut health becomes ever more critical. One of the more recent medical concerns – Spaceflight-Associated Neuro-ocular Syndrome (SANS) – has focused attention on a field once considered secondary in space medicine: vision.
Over the past two decades, visual impairments linked to spaceflight have emerged as a serious issue for crew members on long-duration missions, with symptoms ranging from transient blurring to persistent structural changes in the eye.
Now, as preparations advance for missions to the Moon and Mars, understanding – and ultimately mitigating – SANS has become a biomedical priority for all space agencies. The study of visual impairments associated with spaceflight has a relatively short history, due to several reasons.
Firstly, during the early development of astronautics, medical priorities focused on more immediate concerns, such as preventing pathological changes to the musculoskeletal system in zero gravity and protecting astronauts from space radiation. Only after these primary challenges were addressed did specialists have the opportunity to investigate less obvious changes occurring in astronauts – particularly in the visual sensory system.
Secondly, despite over 60 years of human spaceflight the number of people who have visited space remains relatively small and this makes it difficult to form a representative sample size to detect statistically significant ophthalmological changes.
Thirdly, astronauts typically possess robust constitutions and significant physiological reserves, allowing them to compensate for the negative effects of short term missions during the early years of space exploration. Additionally, the rigorous selection process for cosmonauts and astronauts has often resulted in underreporting of health complaints by active crew members.
 Long-duration astronauts may experience some or all of the changes illustrated in this SANS graphic from NASA.
Long-duration astronauts may experience some or all of the changes illustrated in this SANS graphic from NASA.
Due to these factors, the influence of spaceflight on the visual system received little attention for a long time. However, with the increasing number and duration of orbital missions – and the availability of advanced diagnostic tools – data on astronaut visual impairments has gradually begun to accumulate.
Visual impairments linked to spaceflight have emerged as a serious issue for crew members on long-duration missions
Since 1989, NASA has conducted post-flight surveys of astronauts to identify symptoms of visual impairment. By 2010, approximately 300 ophthalmological questionnaires had been collected. Analysis revealed that around 29 percent of astronauts on short-term missions and 60 percent on long-term missions reported a decrease in visual acuity during or after spaceflight [The Visual Impairment Intracranial Pressure Summit Report, 2011].
Similar findings have emerged in Russia. In 2002, V. Myasnikov and S. Stepanova published research on cerebral blood circulation in cosmonauts who participated in long-duration missions aboard the MIR orbital station. As part of the study, post-flight ophthalmoscopy was conducted on 16 cosmonauts. Eight of them were diagnosed with optic disc oedema. At least three of the 16 showed mild to moderate oedema swelling – approximately 19 percent of the sample.
Previously reported visual impairments among astronauts were generally mild, transient and common in individuals over 40. However, in some cases, these impairments persisted for years after return to Earth and were confirmed by objective diagnostic methods.
The high prevalence of reported visual symptoms prompted NASA to initiate targeted investigations into the causes of these impairments. The revised pre- and post-flight medical protocols included funduscopy, refraction measurements, optical coherence tomography (OCT), orbital magnetic resonance imaging (MRI), and archiving of fundus images before and after missions. These modern methods allowed researchers to objectively confirm changes in the visual system caused by spaceflight.
A landmark study by TH Mader et al. in 2011 examined seven astronauts before and after long-duration missions to the International Space Station (ISS). Six underwent OCT and orbital/cranial MRI post-flight, and four had lumbar punctures to measure intracranial pressure between 12 and 66 days after return.
By 2016, 24 long-duration ISS crew members (those who served more than three months) had visual complaints confirmed by objective research methods [Risk of Spaceflight Associated Neuro-ocular Syndrome, 2017]. Almost all exhibited the following symptoms:
- Reduction in near vision (hypermetropic refractive shift) between +0.50 and +1.75 diopters
- Optic disc oedema of varying severity
- Eyeball flattening as observed via ultrasound
- Choroidal folds (see Fig. 1)
- Retinal tissue swelling resembling cotton-wool spots (in three of six examined).
To further study visual health in orbit, an international research team sent a videofundoscope and an automatic portable tonometer to the ISS. They also developed procedures for in-flight examination of the eyeball and fundus.
 Fig.1 Optic disc oedema.
Fig.1 Optic disc oedema.
Fig.2 Chorioretinal folds on the astronaut’s optical coherence tomography after lengthy space mission [Evidence Report, 2022].
Fig.2 Chorioretinal folds on the astronaut’s optical coherence tomography after lengthy space mission [Evidence Report, 2022].
These systematic, spaceborne investigations led to the identification of a syndrome first described by Mader et al., now known as Spaceflight-Associated Neuro-ocular Syndrome (SANS) [Risk of Spaceflight Associated Neuro-ocular Syndrome, 2017].
As mission durations increase, the risk of developing clinically significant visual impairments may exceed acceptable thresholds
SANS encompasses a set of interrelated morphological and functional changes in the visual sensory system resulting from prolonged exposure to spaceflight conditions. It is now recognised as a unique condition found exclusively in individuals who have spent extended periods in microgravity – unlike any syndrome seen in Earth-bound populations [Risk of Spaceflight Associated Neuro-ocular Syndrome (SANS), Evidence Report, 2022].
 Fig.3 An astronaut’s preflight and postflight MRI. The postflight image shows the bulbus oculi flattening (more pronounced on the right) OD (oculus dexter) – right eye, OS (oculus sinister) – left eye.
Fig.3 An astronaut’s preflight and postflight MRI. The postflight image shows the bulbus oculi flattening (more pronounced on the right) OD (oculus dexter) – right eye, OS (oculus sinister) – left eye.
It has been clearly demonstrated that the duration of space exposure significantly affects the likelihood and severity of SANS. As mission durations increase, the risk of developing clinically significant visual impairments may exceed acceptable thresholds. Consequently, astronauts on long-term ISS missions undergo regular vision checks beginning 30 days into the flight.
Major space agencies around the world are continuing their efforts to understand and mitigate SANS, especially in preparation for future crewed long duration missions to the Moon and Mars.
About the authors
Yuri A Bubeev - Doctor Habilitatus in Medicine, Professor, Corresponding Member of the Russian Academy of Sciences, Deputy Director for academic affairs, Head of the Psychology and Psychophysiology Department of the IBMP RAS, Moscow, Russia,
Alexander E Smoleevsky - Candidate of Medical Science, Leading Expert at the Scientific and Research Institute of Ergatic Systems, Moscow, Russia
Olga M Manko - Doctor Habilitatus in Medicine, Leading Researcher, Head of the Visual System Physiology and Psychophysiology Laboratory, of the IBMP RAS, Moscow, Russia.














